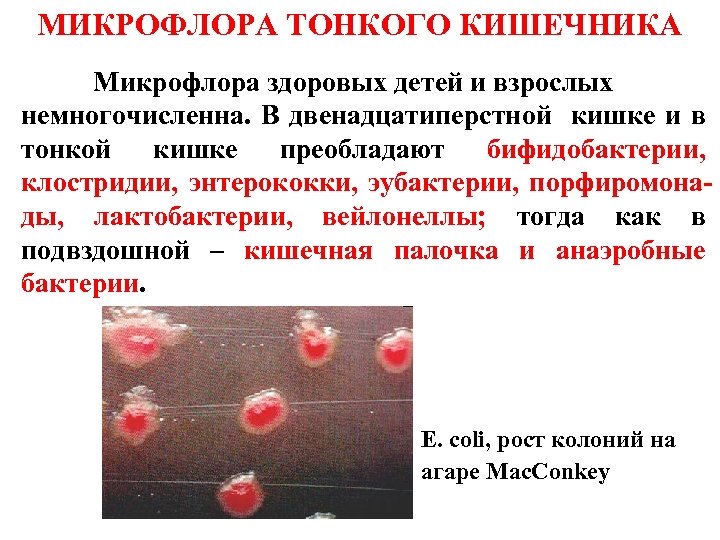
МИКРОФЛОРА ТОНКОГО КИШЕЧНИКА Микрофлора здоровых детей и взрослых немногочисленна. В двенадцатиперстной кишке и в

d7c694a95b3a360d73c7d4c61c075dbf.ppt
- Количество слайдов: 35

Микрофлора организма человека. Дисбактериоз.

План лекции • Формы симбиоза микроорганизмов с макроорганизмом. • Виды микрофлоры. • Микрофлора кожи. • Микрофлора желудочно-кишечного тракта. • Микрофлора дыхательных путей. • Микрофлора конъюнктивы глаза. • Микрофлора мочеполового тракта. • Основные функции нормальной микрофлоры. • Дисбактериоз: определение понятия, причины возникновения, коррекция и лечение дисбактериоза.

ФОРМЫ СИМБИОЗА В отличии от свободноживущих микробов, микробы- симбионты в процессе эволюции приспособились к условиям существования с организмом хозяина. Различают следующие формы симбиоза: Мутуализм (лат. mutuus взаимный) Комменсализм (фр. commensal- сотрапезник) Паразитизм (гр. parasitos -нахлебник) Мутуализм и комменсализм характерны для нормальной микрофлоры организма здорового человека.

КЛАССИФИКАЦИЯ Все многообразие микробов, встречающихся в организме человека, можно разделить на две группы. Резидентная микрофлора Транзиторная микрофлора

ОСНОВНЫЕ ОТДЕЛЫ ОРГАНИЗМА ЧЕЛОВЕКА, ЗАСЕЛЁННЫЕ БАКТЕРИЯМИ, ВКЛЮЧАЮТ: • кожные покровы; • воздухоносные пути; • желудочно-кишечный тракт; • мочеполовую систему.

СВОБОДНЫ ОТ МИКРООРГАНИЗМОВ: • • • КРОВЬ; ЛИМФА; СИНОВИАЛЬНАЯ ЖИДКОСТЬ; СПИНОМОЗГОВАЯ ЖИДКОСТЬ; ВНУТРЕННИЕ ОРГАНЫ; ПЛЕВРАЛЬНАЯ ПОЛОСТЬ. Выделение бактерий из обычно стерильных компартментов, а также глубоких тканей имеет диагностическое значение.

КОЖНЫЕ ПОКРОВЫ На кожных покровах на микроорганизмы воздействуют бактерицидные факторы сального секрета и пота, закисляющие р. Н. В подобных условиях обитают преимущественно: • Staphylococcus epidermidis; • пропионибактерии; • бактероиды; • микрококки; • пептострептококки; • дрожжеподобные грибы; • сарцины; • коринеформные микроорганизмы; • Staphylococcus saprophyticus.

ЗОНЫ КОЛОНИЗАЦИИ КОЖНЫХ ПОКРОВОВ Основными зонами колонизации кожных покровов являются: Ø Ø эпидермис, роговой слой кожи, кожные железы, верхние отделы волосяных фолликулов. Обычно на 1 см 2 выявляют до 80000 микроорганизмов, а на участках с повышенной влажностью их число может достигать миллиона; соблюдение элементарных правил гигиены может снижать число бактерий на 90%.

МИКРОФЛОРА РОТОВОЙ ПОЛОСТИ В ротовой полости на бактерии действует слюна, смывающая их и содержащая большой набор антимикробных веществ. Среди бактерий доминируют -гемолитические стрептококки, составляющие до 60% всей микрофлоры ротоглотки. Встречаются также: q бактероиды, фузобактерии, вейлонеллы, актиномицеты и др. ; q нейссерии, непатогенные коринебактерии, молочнокислые бактерии, стафилококки, спирохеты; q простейшие (Entamoeba buccalis, Entamoeba dentalis, Trichomonas buccalis). Fusobacterium nucleatum, окр. по Граму Постоянные обитатели способны к адгезии поверхности зубов и слизистой оболочки. Состав микрофлоры зависит от состояния организма, состава пищи, гигиены полости рта.

МИКРОФЛОРА ПИЩЕВОДА И ЖЕЛУДКА Микробиоценоз пищевода непостоянен, зависит от характера пищи. Бактерии пищевода соответствуют микрофлоре ротовой полости. Микробиоценоз желудка беден, что обусловлено действием желудочного сока. Число выделяемых организмов не превышает 103/мл. Встречаются: üлактобациллы; Helicobacter pylori, окр. по üстрептококки; Романовскому-Гимза üхеликобактеры; üдрожжеподобные грибы.
МИКРОФЛОРА ТОНКОГО КИШЕЧНИКА Микрофлора здоровых детей и взрослых немногочисленна. В двенадцатиперстной кишке и в тонкой кишке преобладают бифидобактерии, клостридии, энтерококки, эубактерии, порфиромонады, лактобактерии, вейлонеллы; тогда как в подвздошной – кишечная палочка и анаэробные бактерии. E. coli, рост колоний на агаре Мас. Conkey

МИКРОФЛОРА ТОЛСТОГО КИШЕЧНИКА В толстом кишечнике отмечается максимальная концентрация бактерий – 109 -1012/г содержимого. Анаэробы составляют до 97 % всех микроорганизмов. Здесь обитают преимущественно: Факультативные аэробы (3 -5 %) Анаэробы (95 -97 %) Энтеробактерии Энтерококки Стафилококки Бактероиды Бифидобактерии Грибы рода Candida Лактобациллы Грамположительные кокки Клостридии Эубактерии Bacteroides fragilis, окр. по Граму

МИКРОФЛОРА ДЫХАТЕЛЬНЫХ ПУТЕЙ Микроорганизмы, содержащиеся во вдыхаемом воздухе, большей частью задерживаются в полости носа. Постоянными обитателями являются: непатогенные нейссерии; стафилококки; коринеформные бактерии; микрококки; лактобактерии; бактероиды; пептококки, пептострептококки; стрептококки. Стафилококки и дифтероиды со слизистой носовой полости, рост на кровяном агаре. Трахея, бронхи и альвеолы обычно свободны от микробов.

МИКРОФЛОРА КОНЪЮКТИВЫ ГЛАЗА Микрофлора конъюктивы глаза бедна. Лизоцим слёзной жидкости обладает бактерицидным свойством и уничтожает большинство микроорганизмов слизистой оболочки глаза. Обитателями этого биотопа являются: v коринебактерии; v стафилококки. Количество их не бывает большим, но при снижении естественной защиты могут возникать воспалительные процессы и эндогенные инфекции. Corynebacterium xerosis, мазок с конъюктивы глаза окр. синькой Лёффлера

МИКРОФЛОРА МОЧЕПОЛОВОЙ СИСТЕМЫ Микробиоценоз органов мочеполовой системы скуден. Почки, мочеточники, моча в мочевом пузыре стерильны, тогда как в нижней части уретры встречаются: v пептококки, пептострептококки; v бактероиды, дифтероиды; v микобактерии; v стрептококки, стафилококки, фузобактерии. На наружных мужских половых органах часто обнаруживают: v стрептококки; v стафилококки; v микобактерии смегмы, морфологически сходные с микобактериями туберкулеза; v непатогенные трепонемы, которые следует отличать от возбудителя сифилиса.

МИКРОФЛОРА ПОЛОВОГО ТРАКТА Микрофлора влагалища формируется у девочек спустя 12 -24 ч после рождения и состоит из молочнокислых бактерий, полученных от матери при родах. Затем в микробиоценоз влагалища включаются: 1. бифидобактерии; 2. бактероиды; 3. энтерококки; 4. стрептококки; 5. стафилококки; 6. коринебактерии и др. С наступлением половой Lactobacillus acidophilus, мазок со зрелости в составе микрофлоры слизистой влагалища, окр. по превалируют палочки Додер. Граму. ляйна (Lactobacillus acidophilus).

МИКРОФЛОРА ПОЛОВОГО ТРАКТА Различают несколько категорий чистоты влагалища здоровых женщин: 1 -я категория 1. Реакция среды кислая. 2. Много п. Додерляйна. 3. Случайные микроорганизмы. 3 -я категория 1. Реакция среды слабокислая, слабощелочная. 2. Мало п. Додерляйна. 3. Стрептококки, стафилококки, лейкоциты 2 -я категория 1. Реакция среды кислая. 2. Много п. Додерляйна. 3. Присутствуют другие микроорганизмы. 4 -я -категория 1. Реакция среды щелочная. 2. Единичные п. Додерляйна. 3. Стрептококки, стафилококки, энтеробактерии, бактероиды, много лейкоцитов.

ФУНКЦИИ НОРМАЛЬНОЙ МИКРОФЛОРЫ Полезные функции микрофлоры в организме человека неоценимы. К ним относятся: v ферментопродуцирующая; v синтетическая; v защитная; v иммунногенная.

ФЕРМЕНТОПРОДУЦИРУЮЩАЯ ФУНКЦИЯ НОРМАЛЬНОЙ МИКРОФЛОРЫ 1. Лактобактерии нейтрализуют действие фенольных ферментов, поддерживающих разрастание раковых клеток в кишечнике, препятствуют развитию рака молочной железы. 2. Бактериальные протеазы гидролизуют белки и пептиды, последние расщепляются бактероидами до аминокислот и пептидных остатков. 3. Микрофлора участвует в метаболизме азот- и углеродсодержащих соединений, липидов. Метаболизм мочевины в кишечнике происходит за счёт микробных уреаз. 4. Микрофлора участвует в рециркуляции желчных кислот, влияет на холестериновый и билирубиновый метаболизм. 5. Микроорганизмы усиливают перистальтику кишечника.

СИНТЕТИЧЕСКАЯ ФУНКЦИЯ НОРМАЛЬНОЙ МИКРОФЛОРЫ 1. Бифидобактерии синтезируют витамины группы В: никотиновую, фолиевую кислоты, тиамин, биотин, цианкобаламин, а также аминокислоты и белки, обеспечивающие их всасывание. 2. Лактобактерии образуют молочную кислоту, продуцируют лизоцим, леколин, низин, ацидофилин и др. 3. Кишечная палочка способствует синтезу иммуноглобулинов. 4. Микроорганизмы предотвращают канцерогенез. 5. Микрофлора кишечника поддерживает водный, электролитный и кислотно-щелочной балансы в организ-ме.

ЗАЩИТНАЯ ФУНКЦИЯ НОРМАЛЬНОЙ МИКРОФЛОРЫ 1. Нормальная микрофлора участвует в защите от колонизации кожных покровов и слизистых человека патогенными бактериями. Представители нормофлоры продуцируют бактериоцины, лизоцим, обуславливающие антагонистическую активность этих бактерий. 2. Представители нормофлоры в кишечнике конкурируют с патогенной флорой за аргинин, треонин, аспарагиновую кислоту, серин, за область обитания.

ИММУНОГЕННАЯ ФУНКЦИЯ НОРМАЛЬНОЙ МИКРОФЛОРЫ 1. Нормальная микрофлора способствует пролиферации плазматических клеток. 2. Бифидобактерии стимулируют синтез антител к овальбумину. 3. Лактобактерии повышают активность фагоцитов и лимфоцитов. 4. Повышение численности бифидо- и лактобактерий при их недостатке приводит к уменьшению воспалительных процессов слизистой кишечника, увеличению числа В-лимфоцитов в периферической крови. 5. Усиление фагоцитарной активности макрофагов, моноцитов, синтеза цитокинов и иммуноглобулинов, стимуляция клеточных иммунных механизмов защиты.

ОТРИЦАТЕЛЬНОЕ ВЛИЯНИЕ МИКРОФЛОРЫ НА ОРГАНИЗМ ЧЕЛОВЕКА v Способна вызывать развитие инфекционных заболеваний (формирование абсцессов при проникновении микроорганизмов через стенку кишечника после травм или хирургического вмешательства. ) v Продуцируют вредные для организма продукты гниения. v Являются источником эндогенной инфекции. v Способны отщеплять патогенные варианты.

ДИСБАКТЕРИОЗ Состав микробиоценоза организма зависит от состава и качества пищи, курения, употребления алкоголя, нормальной перистальтики и своевременного опорожнения кишечника и мочевого пузыря, качества пережёвывания пищи и даже характера трудовой деятельности. Наибольшее воздействие оказывают заболевания, сопровождающиеся изменением физико-химических свойств эпителиальных поверхностей, а также приём антибиотиков. Нарушение нормального качественного и количественного состава микрофлоры, возникающее под влиянием различных причин, называется ДИСБАКТЕРИОЗОМ (ДИСБИОЗОМ).

ПРИЧИНЫ ДИСБАКТЕРИОЗА Хронические заболевания. Длительное применение антибиотиков и гормональных препаратов.

КОРРЕКЦИЯ ДИСБАКТЕРИОЗА Сформировавшиеся дисбактериозы трудно поддаются коррекции и требуют длительного времени. Наиболее важные условия для восстановления нарушенного микробиоценоза заключаются в следующем: 1. нейтрализация и выведение токсинов и условно-патогенных микроорганизмов, что достигается путём назначения сорбентов; 2. подавление развития патогенной и восстановление баланса собственной микрофлоры с использованием различных видов бактериальной терапии; 3. усиление желчеобразовательной, желчевыделительной и детоксицирующей функции печени; 4. улучшение метаболических процессов в клетках и тканях человека.

ЛЕЧЕНИЕ ДИСБАКТЕРИОЗА В лечении дисбактериоза применяется следующие подходы: • отмена антибактериальных препаратов (по возможности); • десенсибилизирующая терапия; • витаминная терапия; • при необходимости - антибактериальные препараты и бактериофаги направленного действия (селективная деконтаминация); • иммунокоррекция; • пробиотики (дифференцированное применение), пребиотики и синбиотики.

ВИДЫ МИКРОБНЫХ БИОПРЕПАРАТОВ • • Пробиотики Пребиотики Синбиотики Функциональное питание (ранее – эубиотики)

Пробиотики – живые микроорганизмы и вещества микробного происхождения, оказывающие при естественном способе введения позитивные эффекты на физиологические, биохимические и иммунные реакции организма хозяина через стабилизацию и оптимизацию функции его нормальной микрофлоры.

Пребиотики – препараты немикробного происхождения, способные оказывать позитивный эффект на организм хозяина путём селективной стимуляции роста или усиления метаболической активности нормальной микрофлоры кишечника.

Синбиотики – препараты, полученные в результате рациональной комбинации пробиотиков и пребиотиков.

Функциональное питание – систематическое использование продуктов естественного происхождения (пищевые волокна, эйкозапентаноиковая кислота, бифидобактерии, олигосахариды), которые оказывают регулирующее влияние на функции определённых органов, систем или организма в целом.

ПРОБИОТИКИ, ПРИМЕНЯЕМЫЕ ДЛЯ ЛЕЧЕНИЯ ДИСБАКТЕРИОЗА • Бифидосодержащие (монокомпонентные – бифидумбактерин, поликомпонентные – бифифор, линекс, бификол, комбинированные - бифилиз, бифидумбактерин форте, пробифор). • Лактосодержащие (монокомпонентные – лактобактерин, биобактон, гастрофарм, поликомпонентные – ацилакт, комбинированные – кипацид, аципол). • Колисодержашие (монокомпонентные – колибактерин, поликомпонентные – бификол, комбинированные – биофлор). • Из других видов бактерий (монокомпонентные – споробактерин, бактисубтил, поликомпонентные – биоспорин, комбинированные – хилак форте).

ПРЕБИОТИКИ, ПРИМЕНЯЕМЫЕ ДЛЯ ЛЕЧЕНИЯ ДИСБАКТЕРИОЗА • • Лактулоза (дюфалак, лактусан) ПАМБА (парааминометилбензойная кислота) Лизоцим Пантотенат кальция

СИНБИОТИКИ, ПРИМЕНЯЕМЫЕ ДЛЯ ЛЕЧЕНИЯ ДИСБАКТЕРИОЗА • • • Биовестин-лакто Мальтодофилюс Бифидобак Бифидумбактерин мульти-1, 2, 3 Ламинолакт
d7c694a95b3a360d73c7d4c61c075dbf.ppt